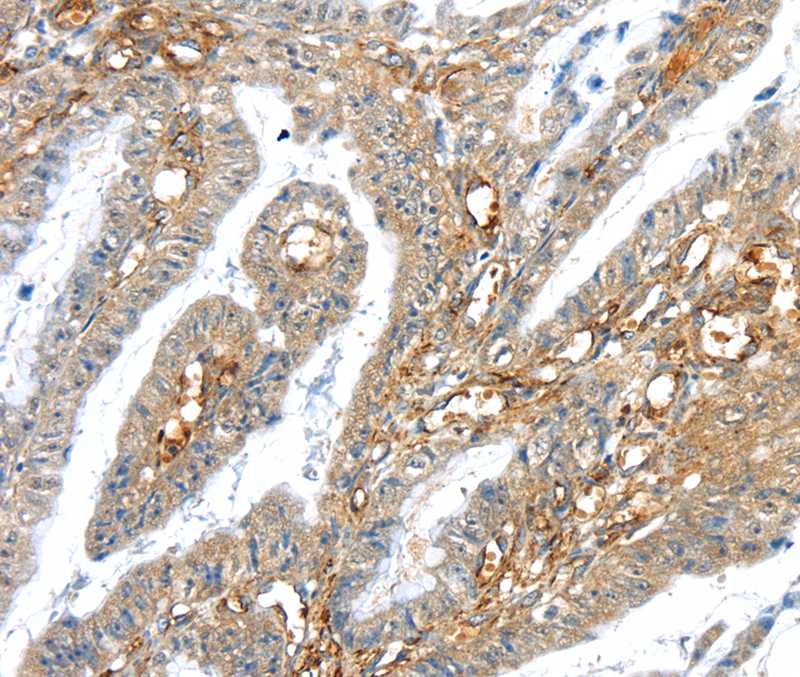
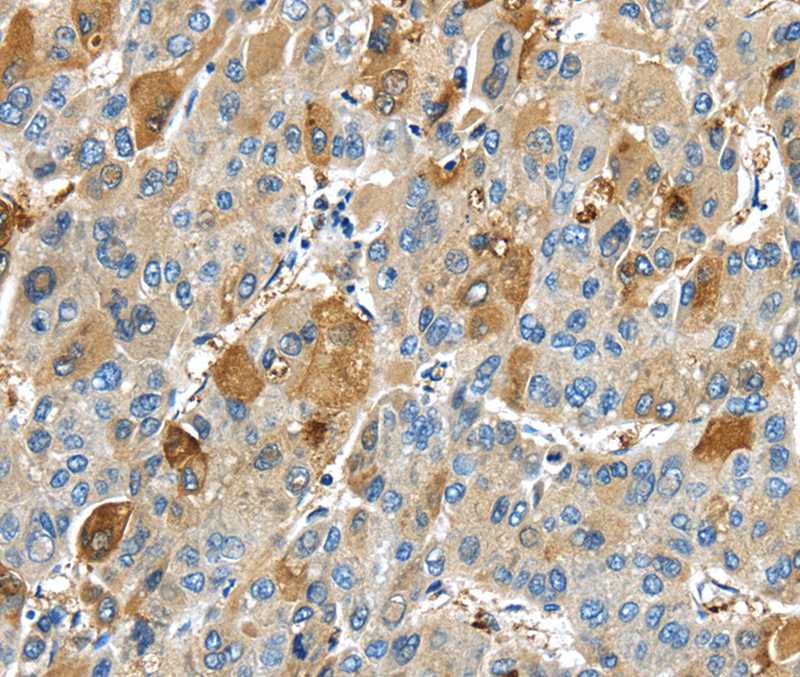

-
分类: 科研抗体货号: P42967别名:应用: WB,IHC,IF反应种属: Human
-
分类: 科研抗体货号: P42966别名:应用: WB,IP,IHC,IF反应种属: Human
-
分类: 科研抗体货号: P42990别名: IL3R; CD123; IL3RX; IL3RY; IL3RAY; hIL-3Ra应用: WB,IHC反应种属: Human,Mouse
-
分类: 科研抗体货号: P42965别名:应用: WB,IHC,IF反应种属: Human
-
分类: 科研抗体货号: P43004别名: GOA; RNF100应用: WB,IHC反应种属: Human,Mouse
-
分类: 科研抗体货号: P42989别名: TRYP2应用: IHC反应种属: Human
-
分类: 科研抗体货号: P42964别名:应用: WB,IHC反应种属: Human,Mouse,Rat
-
分类: 科研抗体货号: P43003别名:应用: WB,IHC反应种属: Human,Mouse,Rat
-
分类: 科研抗体货号: P42988别名: B94; EXOC3L3应用: IHC反应种属: Human
-
分类: 科研抗体货号: P42962别名: Fc fragment of IgE, high affinity I, receptor for; Fc-epsilon RI-gamma; FCER1G; FCERG应用: IHC,IF反应种属: Human,Mouse,Rat

鄂公网安备42018502007531号
鄂公网安备42018502007531号

